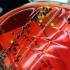

Invităm cititorii la dialog civilizat şi constructiv, bazat pe respect faţă de autori sau alţi cititori. Mesajele care conţin cuvinte obscene, anunţuri publicitare, atacuri la persoană, trivialităţi, jigniri, ameninţări şi cele vulgare, xenofobe sau rasiste sunt interzise de legislaţia în vigoare. Aceste tipuri de comentarii vor fi şterse de către moderatori şi pot duce până la blocarea accesului la a mai posta comentarii pe obiectivbr.ro. Totodată, autorul comentariului îsi asuma eventualele daune, în cazul unor actiuni legale împotriva celor publicate. Pentru a avea acces la comentarii si a putea comenta trebuie sa fiti logati in disqus.com / facebook.com / google.com / twitter.com in browserul in care accesati site-ul nostru.